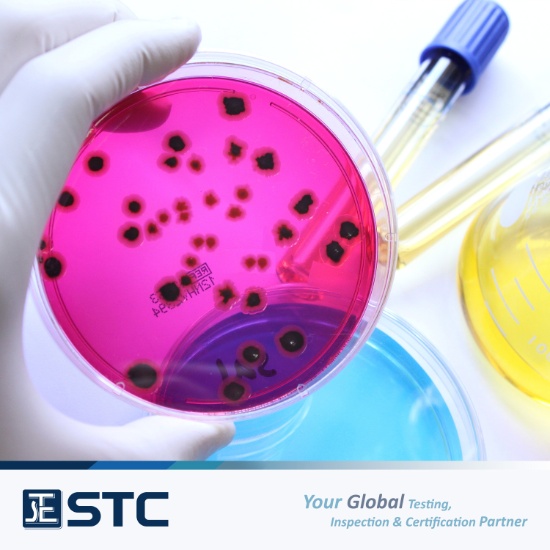

General Foodstuffs Testing
General Foodstuffs Testing
- Aerobic colony count / Anaerobic plate count
- Coliform / Fecal Coliform
- Enterobacteriaceae
- Molds & Yeasts Count
- Mesophilic / Thermophilic Spore Count
Mooncake, Pastry & Bread Testing (GB 19855, GB 7099)
- Aerobic Plate Count (GB 4789.2)
- Coliforms (GB 4789.3)
- Moulds Count (GB 4789.15)
- Salmonella (GB 4789.4)
- Shigella (GB 4789.5)
- Staphylococcus aureus (GB 4789.10)
Biotoxins - Seafood & Shellfish Testing
- Amnesic shellfish poison (ASP)
- Diarrhetic shellfish poison (DSP)
- Neurotoxic shellfish poison (NSP)
- Paralytic shellfish poison (PSP)
Antibacterial Assessment
- Textile Materials (AATCC 100, AATCC 147, JIS L 1902)
- Plastic (JIS Z 2801, ISO 22196)
- Metal & Ceramic Products (JIS Z 2801)
- Assessment of Antimicrobial Activity (ASTM E2315)
Antifungal Assessment
- Textile materials and Fabrics (AATCC 30, ASTM D4576)
- Plastic (ASTM G21)
- Antimicrobial Effectiveness testing for Disinfectant or Sterilization Product
Cosmetics Testing
- Standard Plate Count, Fecal coliforms, Pseudomonas aeruginosa, Staphylococcus aureus (GB 7916)
- Aerobic Bacterial Count, Thermotolerant coliform bacteria, Pseudomonas aeruginosa, Staphylococcus aureus (Molds & Yeast Count Safety and Technical Standards for Cosmetics 2015)
Disposable Products Testing
- Sanitary Products (GB 15979)
- Wooden Chopsticks (GB 19790.1)
Toiletry Testing
- Bathroom Tissue (Including base paper) (GB 20810)
- Toilet Paper (QB 2500)
Antibiotics-Resistant Bacteria
- Extended-spectrum beta-lactamase producing bacteria (ESBL)
- Methicillin-resistant Staphylococcus aureus (MRSA)
Antibiotics-Sensitivity Testing (AST)
- Aminoglycosides
- Carbapenems
- Cephalosporins
- Fluoroquinolones
- Glycopeptides
- Lincosamides
- Macrolides
- Penicillins
- Sulfonamides
- Tetracyclines
Hygiene & Sanitation
- Swab Sampling & Testing
- Hygiene Audit
- On-site Basic Food Hygiene Training
If you have any further question, please feel free contact us at
enquiry@stc.group or visit our website:
https://www.stc.group/en/contact
